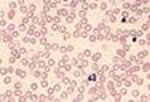

La beta talassemia minor è geneticamente caratterizzata da eterozigosi per un gene beta talassemico.
Può essere diagnosticata solo tramite i dati di laboratorio perchè può non essere accompagnata da anemia e sintomatologia clinica, per questo consente una buona qualità di vita. L'importanza della diagnosi deriva dalla possibilità dell'unione di due individui affetti di avere un figlio con Morbo di Cooley.
Quindi quali esami facciamo per la diagnosi?
- Emocromocitometrico.
- Morfologico del sangue.
- Elettroforesi dell' emoglobina (Hb).
Gli eritrociti sono:
- Piccoli
- Ipocromici
- Marcatamente aumentati rispetto all'Hb.
- Hb: 10-12 g \dl, in alcuni casi ha valori nella norma.
- Aumento degli eritrociti
- Microcitosi
- Ipocromia
- Poichilocitosi
- Emazie con punteggiature basofile per la precipitazione delle catene alfa
- Aumento delle resistenze globulari osmotiche
- Fenotipo emoglobinico caratterizzato dall'aumento dell'HbA2.
- Lieve astenia
- Facile esauribilità fisica
- Subittero
- Lieve splenomegalia.
Non esiste una terapia per la beta talassemia minor, può essere utile la somministrazione periodica di vitamina B12 ed acido folico per evitarne la carenza.
[Bibliografia: Corso di malattie del sangue e degli organi emolifopoietici - ESCULAPIO]
Immagini by Google.
Nessun commento:
Posta un commento